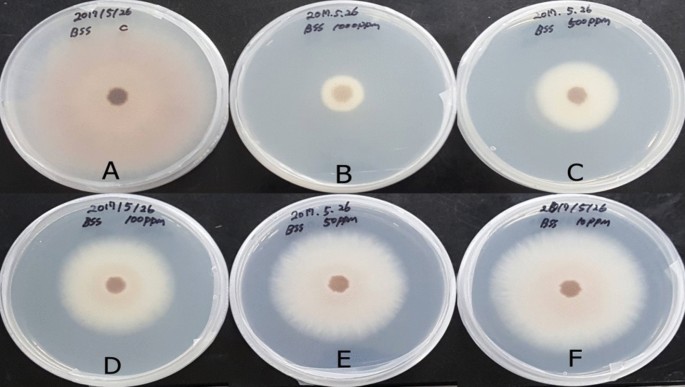
figure 1

- Article
- Open access
- Published:
Identification of antifungal constituents of essential oils extracted from Boesenbergia pulcherrima against Fusarium wilt (Fusarium oxysporum)
Applied Biological Chemistry volume 63, Article number: 34 (2020)
Abstract
With the aim of developing environment-friendly agricultural products with antifungal activity against Fusarium oxysporum f. sp. lycopersici, a causative agent of Fusarium wilt, active substances from Boesenbergia pulcherrima roots were isolated. The hexane fraction from B. pulcherrima root extract was analyzed by GC/MS. The main peaks were estimated and identified to be methyl eugenol, methyl isoeugenol, elemicin, α-asarone, and 1,2-dimethoxy-4-(2-methoxyethenyl)benzene based on the Wiley library and by comparing retention times and mass spectra with their corresponding standards using GC/MS. For the identification of the compound in peak D that was estimated to be 1,2,4-trimethoxy-5-vinylbenzene, for which no reference standard was available, the hexane fraction was processed by column chromatography before NMR analysis. The result confirmed the compound to be 1,2,4-trimethoxy-5-vinylbenzene. Almost all compounds showed antifungal activity against F. oxysporum based on bioassays, and α-asarone had the highest activity. Therefore, B. pulcherrima root extract can be a potential source of environment-friendly agricultural products with antifungal activity against F. oxysporum.
Introduction
Fusarium wilt affects strawberry, radish, Chinese cabbage, watermelon, and similar plants. Under relatively warm and high humidity conditions, the disease rate increases and the host range is widened, resulting in damage to many crops. An imbalance in the soil moisture content stresses and weakens plants, thereby damaging the roots [1].
Fusarium fungi, the major causative agents of wilt disease, were first reported by Link [2]; about 142 species have been identified as incomplete fungi. Wollenweber and Reinking [3] divided 600 varieties of Fusarium into 16 varieties and classified them into groups of 65, 55, and 22 species [4,5,6]. Especially, wilt caused by Fusarium oxysporum f. sp. lycopersici is common in Europe, the United States, and Japan. Among the microorganisms present in the soil, pathogens are highly adaptable to environment and are very difficult to control; moreover, their host range is very wide. These pathogens survive even under low temperatures for many years in the soil as blackspot spores [7,8,9,10]. These pathogens damage the roots and ducts of infected plants, and when the underlying leaves wither and degrade, the diseased roots or stems can cause the entire plant to turn black, leading to the death of the entire plant [11]. This occurs in a variety of overculture plantations. F. oxysporum is most recognized soil pathogen which cause tomato plants diseases, resulting in the loss of plant life [12]. The chemical control method for wilt disease is not an effective short-term control method, yet soil fumigation using chloropicrin, methyl bromide, and methane sodium is most commonly practiced [13]. However, resultant toxicity to humans and animals and adverse effects on the soil environment has increased the demand for environment-friendly soil disease control technology.
Boesenbergia pulcherrima (Wall.) Kuntze used in this study was first reported under the name of Gastrochilus Wall. Zingiberaceae [14]. It has a taxonomic origin in Myanmar and is mainly found in tropical countries, such as Laos, Myanmar, and India. It is often distributed in mountainous areas of semi-wetlands with bamboo species and blooms between August and November [15].
Whole plants of the Boesenbergia genus have been studied through DNA and taxonomical analyses [16] for their use in folk medicine [17], but antifungal potentials of its ingredients have not been explored. Therefore, this study was carried out to identify antifungal components from B. pulcherrima that are active against F. oxysporum and to utilize them for the development of eco-friendly fungicides.
Materials and methods
Materials
Fusarium oxysporum pathogen was obtained from the Division of Biotechnology the National Agrobiodiversity Center. It was stored and cultivated at the Natural Product Chemistry Lab of Plant Resources Environment Department, Graduate School of Ecology and Environmental System, Kyungpook National University.
Identification of B. pulcherrima
A sample of B. pulcherrima was submitted to the Overseas Biological Resource Center of the Korea Biotechnology Center for gene analysis. DNA was extracted to identify the gene sequence of the sample (Dneasy Plant Handbook, 2006). Extracted DNA was amplified through PCR to the ITS1 and ITS2 region, which is the target molecule marker region. Obtained PCR product was purified using Minelute PCR purification kit. Cyclic sequencing reaction procedure was performed and the product was purified using ethanol/EDTA/sodium acetate precipitation method. Sequence chromatogram was obtained from a sequencing product supplier. Sequence chromatograms were sequenced using Sequencher program (Ver.4.9; Gene Codes Corp., USA).
Reagents and equipment
Reference standards, such as methyl eugenol, methyl isoeugenol, elemicin, and α-asarone, were purchased from Sigma-Aldrich Chemicals (St. Louis, MO, USA), and the reference drug Topsin M was purchased from Kyongnong (Seoul, Korea). Solvent for fractionation, silica gel column chromatography such as methanol(MeOH), n-hexane, chloroform(CHCl3), ethyl acetate(EtOAc), and n-butanol(n-BuOH) grade were purchased from Duksan Company (Ansan, Korea). The 600 MHz DMX-600 NMR spectrometer (Varian Bruker, MA, USA) was used for NMR spectroscopy; tetramethyl silane (TMS) was used as an internal standard, and the chemical shift is expressed in ppm (δ). Potato dextrose agar (PDA) medium (Becton–Dickinson & Co, MD, USA), 185-mm Ø, No. 2 filter paper (Advantec, Tokyo, Japan), and petri dishes (SPL, Pocheon, Korea) were used for the bioassays. Analyses were performed using a Agilent 7890A GC system (Agilent, CA, USA) with HP-5MS capillary column, Agilent 5975C detector, and the Wiley library (NIST11.L). GC–MS temperature of the oven at the time of analysis. 70–230 Mesh silica gel (Merck, Darmstadt, Germany) was used to isolate antifungal active compound by column chromatography.
Pathogen culture conditions
For pathogen culture, the PDA culture medium was prepared in petri dishes, and the fungal strain was inoculated with a cork borer (8 mm), cultured in the middle of the medium, and then used after incubation at 18 °C.
MeOH solvent extraction
Dried B. pulcherrima sample (1 kg) was finely pulverized using a blender, immersed in 99.5% MeOH at room temperature for 24 h, and then extracted thrice. The supernatant was filtered using a filter paper, and the filtrate was concentrated under reduced pressure on a rotary evaporator at 40 °C to obtain the MeOH extract (73.74 g).
Solvent fractionation
MeOH extract (73.74 g) was dissolved in 500 ml of distilled water. n-hexane, CHCl3, EtOAc, n-BuOH were fractioned, respectively. In result, -hexane fraction 37.97 g, CHCl3 fraction 10.08 g, EtOAc fraction 3.27 g, n-BuOH fraction 6.08 g, Aqueous layer 16.34 g were obtained.
Antifungal activity search
The hexane fraction obtained by solvent fractionation of the MeOH extract from B. pulcherrima roots was analyzed by GC/MS. The peaks obtained by GC/MS were compared with the Wiley library database (NIST11.L) to profile the antifungal active substance.
Preparation of antifungal substance
Among the compounds detected by GC/MS analysis and among the compounds presumed to be antifungal active substances, commercially available standards (methyl eugenol, methyl isoeugenol, elemicin, and α-asarone) were purchased and analyzed by GC/MS. Components that could not be purchased were independently separated, purified, and their structures were determined by NMR analysis.
Separating and refining peak D compound
In order to confirm the structure of the compound by NMR analysis, peak D compound, which was presumed to be 1,2-dimethoxy-4-(2-methoxyethenyl)benzene, silica gel (Merck 7734, 700 g) was packed in a glass column (50 mm Ø × 860 mm) and 37.97 g of hexane fraction, confirmed to contain the peak D compound, was dissolved in hexane and loaded on a column chromatograph. Hexane:CHCl3 (1, 10, 20, 30,…, 50% in CHCl3, v/v) solvent mix was used to obtain 100 fractions (HS—1,…, HS-100) in 150-ml increments. Among the 100 fractions, 6.09 g of HS-80 fraction, containing peak D compound, was loaded in an open column (30 mm Ø × 860 mm) filled with 200 g silica gel. Hexane:CHCl3 (1: 9, v/v) was used to obtain 60 subfractions (HS-80-1,…, HS-80-60) in 15-ml increments. Out of the 60 subfractions, subfraction HS-80-50 was completely separated.
Antifungal bioassay
All compounds were added to autoclaved PDA medium at concentrations of 0, 1, 5, 10, 50, 100, and 1000 ppm in petri dishes (90 mm × 15 mm). After the medium was completely solidified, the experimental fungal strain was placed in the middle of the agar plate by using a cork borer (8 mm). The agar plate was placed in an incubator at 18 °C, and antifungal activity was investigated by measuring the growth rate of the strain over 10 days.
Results and discussion
Antifungal activities of the MeOH extract of B. pulcherrima roots
Boesenbergia Pulcherrima roots were extracted thrice in MeOH, and the extract was concentrated to 0, 10, 50, 100, 500, and 1000 ppm. The test strain F. oxysporum was placed in the center of the growth medium containing the antifungal sample and cultured for 10 days at 18 °C for examining the antifungal activity (Fig. 1). The MeOH extract at all concentrations inhibited the of growth of F. oxysporum fungi compared with control, and the EC50 value was 69.45 ppm.
Sequence analysis and construction of the phylogenetic tree
We analyzed B. pulcherrima roots by PCR, then parsed to analyze the base sequence and compared it to the nucleotide BLAST sequences of NCBI; higher than 99% hierarchy was observed. As a result of the preparation of molecular counting and comparing the internal transcribed spacer area with those of other Boesenbergia species, it was confirmed that our sample belonged to B. pulcherrima (Fig. 2).
Profiling of antifungal active substances in the hexane fraction of B. pulcherrima root extract
To explore the antifungal active substances of the hexane fraction obtained from the MeOH extract of B. pulcherrima roots, the active substances were isolated and analyzed by GC/MS (Fig. 3). It was assumed that peak A peak (9.729 min) was methyl eugenol, peak B (10.913 min) was methyl isoeugenol, peak C (11.709 min) was elemicin, peak D (11.857 min) was 1,2-dimethoxy-4-(2-methoxyethenyl)benzene, peak E (12.647 min) was isoelemicin, peak F (13.711 min) was β-asarone, and peak G (13.711 min) was α-asarone. To identificate these substance, methyl eugenol, methyl isoeugenol, elemicin, α-asarone, commercially sold products, were purchased to compare through GC–MS analysis. 1,2-dimethoxy-4-(2-methoxyethenyl) benzene, which is not commercially not sold products, were isolated through NMR by structure identification.
Identification of antifungal substances
GC Retention times and mass spectra of reference standards methyl eugenol (9.734 min), methyl isoeugenol (10.930 min), elemicin (11.709 min), and α-asarone (13.688 min) matched with those of peak A (9.729 min), peak B (10.913 min), peak C (11.697 min), and peak G (13.699 min), respectively (Additional files 1, 2, 3, 4). Although peak E and peak F were identical with standard elemicin, α-asarone mass spectrum, retention time were different from standard product. Elemicin isomer, isoelemicin, was isolated from peak E. α-asarone isomer, β-asarone was isolated from peak. Peak D was estimated as 1,2-dimethoxy-4-(2-methoxyethenyl)benzene. However, this product was not available for purchase; therefore, it was directly isolated from the extract, and analyzed by NMR.
1H-NMR analysis revealed proton peaks at chemical shifts of 6.98, 5.60, and 5.17 ppm (attributable to benzene), 7.02 ppm and 6.51 ppm (vinyl group), and 3.90, 3.87, and 3.83 ppm (methoxy group). 13C-NMR analysis showed that there were six carbon peaks attributed to benzene at chemical shifts of 97.83–151.45 ppm, two carbon peaks of vinyl groups at chemical shifts of 112.09 and 130.99 ppm, and three carbon peaks attributed to the methoxy group at chemical shifts of 56.76, 56.53, and 56.11 ppm. As a result, the peak D compound was structurally analyzed to be 1,2,4-trimethoxy-5-vinylbenzene (Additional file 5). Therefore, this is the first report of structural analysis and isolation of methyl eugenol, methyl isoeugenol, elemicin, isoelemicin, α-asarone, β-asarone, and 1,2,4-trimethoxy-5-vinylbenzene from B. pulcherrima roots (Fig. 4).
Bioassay of compounds separated from B. pulcherrima roots
Methyl eugenol, methyl isoeugenol, elemicin, α-asarone, and 1,2,4-trimethoxy-5-vinylbenzene were isolated from B. pulcherrima roots. In order to test their antifungal activities against the wilt pathogen F. oxysporum, PDA was spiked with 0, 1, 5, 10, 50, and 100 ppm of purified 1,2,4-trimethoxy-5-vinylbenzene and standards for methyl eugenol, methyl isoeugenol, elemicin, and α-asarone. A commercially available agricultural fungicide (Topsin M) was purchased and used as a positive control. The test strain F. oxysporum was inoculated at the center of the medium and cultured at 18 °C for 10 days in the presence of the test compounds (Fig. 5; Table 1).
The inhibitory effects of methyl eugenol, methyl isoeugenol, elemicin, 1,2,4-trimethoxy-5-vinylbenzene, and α-asarone compounds on F. oxysporum, a soil pathogen causing Fusarium wilt that damages most vegetables and flowers, were investigated. α-Asarone showed the highest antifungal activity, followed by elemicin.
Essential oils have been known for long time to possess antifungal activity. Methyl eugenol and methyl isoeugenol have similar antifungal activity against seven species fungus, Blastomyces dermatitidis, Histoplasma capsulatum, Fonsecaea pedrosoi, Aspergillus nidulans, Penicillium frequentans, and Penicillium cyclopium at 2.0 mM concentration [22, 23]. In addition, α-Asarone revealed 85 and 52% of the control values against Phytophthora infestans in vivo at 1000 and 500 ppm, respectively, but no inhibition of the growth of Pyricularia grisea, Botrytis cinerea, Puccinia recondita, Erysiphe graminis [24]. Elemicin observed no antifungal activity against Cladosporium cladosporioides [25]. α-Asarone is found in Acorus calamus. It is a typical essential oil that has bactericidal, insecticidal, and antifungal activity. It has pharmacological effects on central nervous system disorders, such as dementia [18,19,20]. 1,2,4-Trimethoxy-5-vinylbenzene has been reported in Duguetia lanceolata and has been reported to be active against spotted mites [21].
With the result obtained from the previous studies and current study, one particular extracts from essential oils does not show highest antifungal activity against the fungal pathogens. Each extract has different antifungal activities against the pathogens. In this study reveal that B. pulcherrima could be developed as an environment-friendly organic product having antifungal activity against F. oxysporum, which is a cause of Fusarium wilt.
Availability of data and materials
The datasets used and analyzed during the current study are available from the corresponding author on the reasonable request.
References
Ploetz RC (2007) Diseases of tropical perennial crops: challenging problems in diverse environments. Plant Dis 91:644–663
Link HF (1809) Observationes in ordines plantarum naturales. Dissertatio I. Mag Ges Naturf Freunde 3:3–42
Wollenweber HW, Reinking OA (1935) Die Fusarien, ihre Beschreibung. Schad-wirkung und Bekämpfung, Paul Parey
Nelson PE (1991) History of Fusarium systematics. Phytopathology 81:1045–1048
Snyder WC, Hansen HN (1945) The species concept in Fusarium with reference to discolor and other sections. Am J Bot 32:657–666
Min BR (1989) Chromosomal studies on the genus Fusarium (I). Korean J Med Mycol 14:253–256
Garibaldi A, Gilardi G, Gullino ML (2002) First report of Fusarium oxysporum on lettuce in Europe. Plant Dis 86:1052
Huang JH (1998) Wilt of lettuce caused by Fusarium oxysporum in Taiwan. Plant Pathol Bull 7:150–153
Lee SH, Kim KY, Ryu SY, Yoon Y, Hahm DH, Kang SA, Cho SH, Lim JS, Moon EY, Yoon SR, Lee GH, Yoon DY, Yang Y (2010) Asarone inhibits adipogenesis and stimulates lipolysis in 3T3-L1 adipocytes. Cell Mol Biol 56:1215–1222
Matuo T (1967) On Fusarium oxysporum f. sp. lactucae n. f. causing root rot of lettuce. Trans Mycol Soc Jpn 32:13–15
Agrios GN (2005) Plant pathology, 5th edn. Academic Press, San Diego. https://doi.org/10.1016/j.plantsci.2005.02.019
Kim HH, Jeon HY, Yang CY, Kang TJ, Han YK (2009) Transmission of Fusarium oxysporum by the Fungus Gnat, Bradysia difformis (Diptera: Sciaridae). Res Plant Dis. https://doi.org/10.5423/rpd.2009.15.3.262
Ben-Yephet Y, Reuven M, Genizi A (1994) Effects of inoculum depth and density on fusarium wilt in carnations. Phytopathology. https://doi.org/10.1094/phyto-84-1393
Wallich N (1829) Plantae Asiaticae Rariores 1 2. Treuttel Würtz Treuttel jun. Richter vol. 1
Mood JD, Tanaka N, Aung MM, Murata J (2016) The genus Boesenbergia (Zingiberaceae) in Myanmar with two new records. Gard Bull. https://doi.org/10.3850/s2382581216000235
Ngamriabsakul C, Techaprasan J (2006) The phylogeny of Thai Boesenbergia (Zingiberaceae) based on petA-psbJ spacer (chloroplast DNA). Songklanakarin J Sci Technol 28:50–57
Trakoontivakorn G, Nakahara K, Shinmoto H, Takenaka M, Onishi-Kameyama M, Ono H, Yoshida M, Nagata T, Tsushida T (2001) Structural analysis of a novel antimutagenic compound, 4-hydroxypanduratin A, and the antimutagenic activity of flavonoids in a Thai spice, fingerroot (Boesenbergia pandurata Schult.) against mutagenic heterocyclic amines. J Agric Food Chem. https://doi.org/10.1021/jf010016o
Phongpaichit S, Pujenjob N, Rukachaisirikul V, Ongsakul M (2005) Antimicrobial activities of the crude methanol extract of Acorus calamus Linn. J Sci Technol 27:517–523
Cho J, Kim YH, Kong JY, Yang CH, Park CG (2002) Protection of cultured rat cortical neurons from excitotoxicity by asarone, a major essential oil component in the rhizomes of Acorus gramineus. Life Sci. https://doi.org/10.1016/S0024-3205(02)01729-0
Raal A, Orav A, Gretchushnikova T (2016) β-Asarone content and essential oil composition of Acorus calamus L. rhizomes from Estonia. J Essent Oil Res 28:299–304
Alves DS, Morejón RC, Machado ART, Carvalho GA, Pina O, Oliveira DF (2015) Acaricidal activity of Annonaceae fractions against Tetranychus tumidus and Tetranychus urticae (Acari: Tetranychidae) and the metabolite profile of Duguetia lanceolata (Annonaceae) using GC–MS. Semin Ciências Agrárias 36:4119–4132
Tan KH, Nishida R (2011) Methyl eugenol: its occurrence, distribution, and role in nature, especially in relation to insect behavior and pollination. J Insect Sci 12:1–37
Kurita N, Miyaji M, Kurane R, Takahara Y (1981) Antifungal activity of components of essential oils. Agric Biol Chem 45:945–952
Lee HS (2007) Fungicidal property of active component derived from Acorus gramineus rhizome against phytopathogenic fungi. Biores Technol 98:1324–1328
Jayasinghe L, Kumarihamy BMM, Jayarathna KHRN, Udishani NWMG, Bandara BMR, Hara N, Fujimoto Y (2003) Antifungal constituents of the stem bark of Bridelia retusa. Phytochemistry 62:637–641
Acknowledgements
Not applicable.
Funding
No funding was received for the current study.
Author information
Authors and Affiliations
Contributions
YHC designed and supervised the experiment. CJP and HSK carried out the experiments. DWL analyzed the data resulted from the experiments. YHC and JK wrote the manuscript. All authors read and approved the manuscript.
Corresponding author
Ethics declarations
Ethics approval and consent to participate
Not applicable.
Consent for publication
Not applicable.
Competing interests
The authors declare that they have no competing interests.
Additional information
Publisher's Note
Springer Nature remains neutral with regard to jurisdictional claims in published maps and institutional affiliations.
Appendix
Appendix
NMR data of compound D: Analyzed by AV600 NMR (Varian Bruker); Solvent: CDCl3; Internal standard: TMS
EI-MS m/z 194.1 [M]+; 1H-NMR (600 MHz, CDCl3) δ 7.02 (1H, s, H-6), 6.98 (1H, t, J = 10.8 Hz, H-7), 6.51 (1H, s, H-3), 5.60 (1H, s, H-3), 5.60 (1H, dd, J = 1.2, 18.0 Hz, H-8b), 5.17 (1H, dd, J = 1.2, 10.8 Hz, H-8a), 3.90 (3H, s, 1-OCH3), 3.87 (3H, s, 4-OCH3), 3.83 (3H, s, 2-OCH3); 13C-NMR (150 MHz, CDCl3); δ 151.5 (C-2), 149.7 (C-4), 143.4 (C-1), 131.0 (C-7), 118.7 (C-5), 112.1 (C-8), 109.6 (C-6), 97.8 (C-3), 56.7 (2-OCH3), 56.5 (1-OCH3), 56.1 (4-OCH3).
Rights and permissions
Open Access This article is licensed under a Creative Commons Attribution 4.0 International License, which permits use, sharing, adaptation, distribution and reproduction in any medium or format, as long as you give appropriate credit to the original author(s) and the source, provide a link to the Creative Commons licence, and indicate if changes were made. The images or other third party material in this article are included in the article's Creative Commons licence, unless indicated otherwise in a credit line to the material. If material is not included in the article's Creative Commons licence and your intended use is not permitted by statutory regulation or exceeds the permitted use, you will need to obtain permission directly from the copyright holder. To view a copy of this licence, visit http://creativecommons.org/licenses/by/4.0/.
About this article
Cite this article
Park, Cj., Kim, Hs., Lee, D.W. et al. Identification of antifungal constituents of essential oils extracted from Boesenbergia pulcherrima against Fusarium wilt (Fusarium oxysporum). Appl Biol Chem 63, 34 (2020). https://doi.org/10.1186/s13765-020-00518-w
Received:
Accepted:
Published:
DOI: https://doi.org/10.1186/s13765-020-00518-w